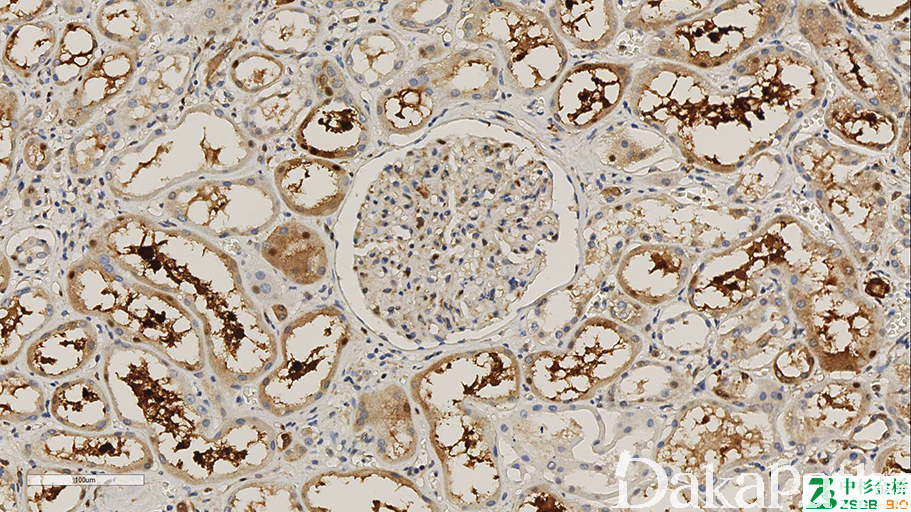

osteopontin


别名: OPN;骨桥蛋白
概述:
骨分化标记物
信号定位: 胞浆
在病理学中的应用:
骨分化标记物,但特异性和敏感性有限。
商品化试剂(排名不分先后,本网站对抗体质量不负责!)
公司 | 克隆号 | 即用型(ml) | 原液(ml) | ||||
中杉金桥 | Akm2A1 | 1.5 | 3 | 6 | / | 0.1 | 0.2 |
EP106 | |||||||
福建迈新 | 多克隆 | / | / | / | / | / | 0.2 |
 知识库
知识库
别名: OPN;骨桥蛋白
概述:
骨分化标记物
信号定位: 胞浆
在病理学中的应用:
骨分化标记物,但特异性和敏感性有限。
商品化试剂(排名不分先后,本网站对抗体质量不负责!)
公司 | 克隆号 | 即用型(ml) | 原液(ml) | ||||
中杉金桥 | Akm2A1 | 1.5 | 3 | 6 | / | 0.1 | 0.2 |
EP106 | |||||||
福建迈新 | 多克隆 | / | / | / | / | / | 0.2 |